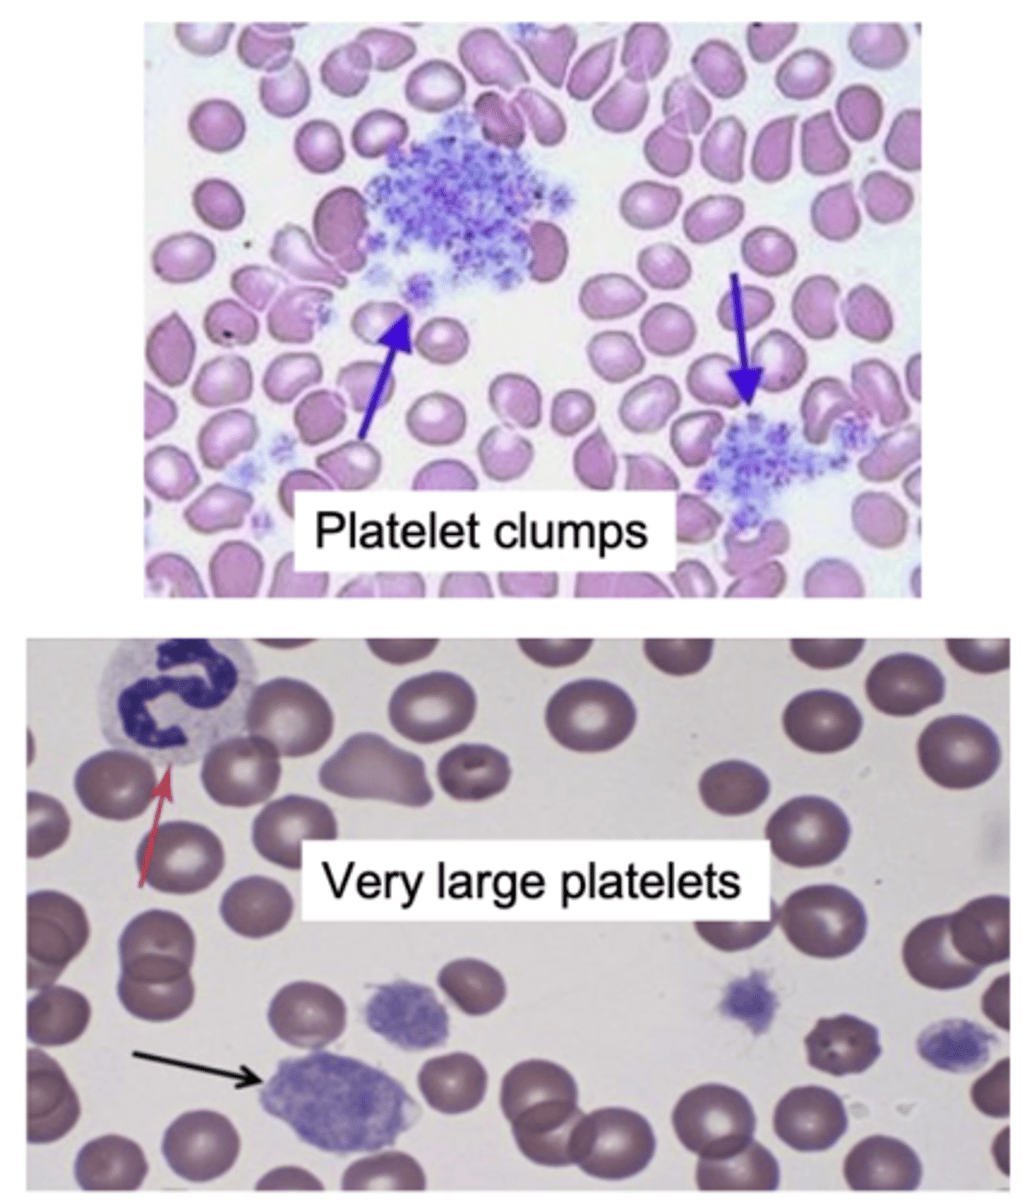
<p>1.) clumped or large platelets</p><p>2.) clumped erythrocytes</p><p>(agglutination)</p><p>3.) excessive Heinz bodies</p>

1/46
Looks like no tags are added yet.
Name | Mastery | Learn | Test | Matching | Spaced | Call with Kai |
|---|
No analytics yet
Send a link to your students to track their progress
Leukocytes
aka white blood cells
Three types of leukocytes
1.) granulocytes
2.) monocytes
3.) lymphocytes
granulocytes
A group of leukocytes containing granules in their cytoplasm
Granules of granulocytes
appearance of the granules is different due to variations in the way the they interact with dye used to stain the cells (acidic, basic, neutral); help identify type of granulocyte
granulocytes have ________ nuclei
segmented
There are four types of granulocytes:
1.) neutrophils
2.) eosinophils
3.) basophils
4.) heterophils
heterophils
Similar to neutrophils but found in birds, reptiles, and some small mammals
monocytes will differentiate into two cell types:
1.) dendritic cells
2.) macrophages
lymphocytes will differentiate into two cell types:
1.) T cells
2.) B cells
Four lymphocyte parameters on a CBC:
1.) total leukocyte count
2.) leukocyte differential
3.) absolute leukocyte numbers
3.) leukocyte morphology
Leukogram
the WBC portion of a CBC

total leukocyte count
# of all WBCs/volume of blood
The total leukocyte is aka..
Total Nucleated Cell Count; some CBC analyzers will count each cell with a nucleus
*normally, the only cells in mammalian blood with nuclei are WBCs, but exception is if there is an increase in nucleated RBCs
If nucleated RBCs are greater than ___%, there is a corrected total leukocyte count
5%
Equation for corrected total leukocyte count
nucleated cell count x (100 ÷ [nRBC + 100])
leukocyte differential
percentage of each type of leukocyte in the blood
absolute leukocyte numbers
# of cells/volume blood for each type of leukocyte; most important value as clinicians!
Three ways to determine the total leukocyte count:
1.) Automated counting methods (CBC analyzers)
2.) Manual counting method
3.) Visual estimate using a blood smear
Automated counting methods (CBC analyzers) of determining total leukocyte count:
automated counts are performed using a machine; most major laboratories
Example of machines used to count total leukocytes
-IDEXX ProCyte
-ADVIA
Pro of using automated counting methods to determine total leukocyte count:
results are more reproducible and accurate (<5% error)
Two cons of using automated counting methods to determine total leukocyte count:
1.) slightly more expensive
2.) doesn't work with non-mammalian samples
Why doesn't using automated counting methods to determine total leukocyte count work with non-mammalian samples?
all the cells will be nucleated (RBCs and thrombocytes), so won't be able to differentiate from WBCs
Manual counting method of determining total leukocyte count:
take whole blood and dilute it with a Unopette system; once blood is diluted, it is placed in a hemocytometer and number of cells in a specified volume are counted with microscope
hemocytometer
specialized, etched glass microscope slide used for manually counting cells
Pros of manual counting method of determining total leukocyte count (3):
1.) easy
2.) inexpensive
3.) can be done in clinic
Con of manual counting method of determining total leukocyte count:
not as accurate or reproducible as automated method
Four reasons why a lab would use manual count to determine total leukocyte count:
1.) if the lab/practice is calibrating a new automated instrument (to make sure it is accurate)
2.) backup method (ex: instrument is down)
3.) non-mammalian samples
4.) double-check automated method
Equation to determine total leukocyte count using manual count
Total WBC x % of WBC type = absolute number for each WBC type
Absolute value of leukocyte count
provides the best evaluation of the leukogram; this value reflects the proportion of each type of WBC in relationship to the total WBC count

Example calculations of absolute value of leukocyte count:
Total leukocyte count for patient = 9,000 WBC/μL
Neutrophil: 65%
Lymphocyte: 30%
Eosinophil: 1%
Monocyte: 4%
Neutrophil: 9000 x 0.65 = 5,850 cells/μl
Lymphocyte: 9000 x 0.3 = 2,700 cells/μl
Eosinophil: 9000 x 0.01 = 90 cells/μl
Monocyte: 9000 x 0.04 = 360 cells/μl
Visual estimate using a blood smear of determining total leukocyte count:
least accurate of all methods; blood smear needs to be well made in order to count all WBCs
Mistakes when making a blood smear that can lead to errors in WBC count
-small volume used
-leukocytes should be evenly distributed, not pushed to the feathered edge
Methods of counting leukocytes on blood smear
1.) count the WBCs in 10 fields and calculate the average
OR
2.) using 10x objective, if there are 20-50 WBC per field is it normal
Leukocytosis
increased total WBC count above the reference interval
Leukopenia
decreased total WBC count below the lower reference interval
Panleukopenia
a decrease in all individual WBC types below each of their reference intervals
One thing that can cause a false decrease in leukocyte count:
clumped or fragile leukocytes; clumps may be counted as a single cell or fragile leukocytes that lyse would not be counted at all

Three things that can cause a false increase in leukocyte count:
1.) clumped or large platelets
2.) clumped erythrocytes
(agglutination)
3.) excessive Heinz bodies
What species type has neutrophils as the highest leukocyte number?
carnivores
What species has equal number of neutrophils and lymphocytes?
horses
What species type has lymphocytes as the highest leukocyte number?
ruminants and rodents
Life cycle of a blood sample in a teaching hospital
blood is submitted to the lab, automated analyzer performs total WBC count, and a lab tech looks at blood smear to confirm WBC count and look for abnormal cell morphology
Life cycle of a blood sample in private practice + reference lab
blood is submitted to reference lab, automated analyzer performs total WBC count, and lab tech looks at blood smear to confirm WBC count; if there is abnormal morphology, it may go to a pathologist for review
Life cycle of a blood sample in private practice + POC analyzer
Blood is run on in-clinic analyzer (ProCyte), automated analyzer performs total WBC count
*ideally, someone looks at blood smear if CBC is abnormal to confirm % of leukocytes and to look for abnormal cell morphology
Life cycle of a blood sample in shelter medicine
Usually no automated analyzer; do a PCV and TS, make a blood smear, and estimate WBC using blood smear

What WBC change does
this patient have?
Leukocytosis